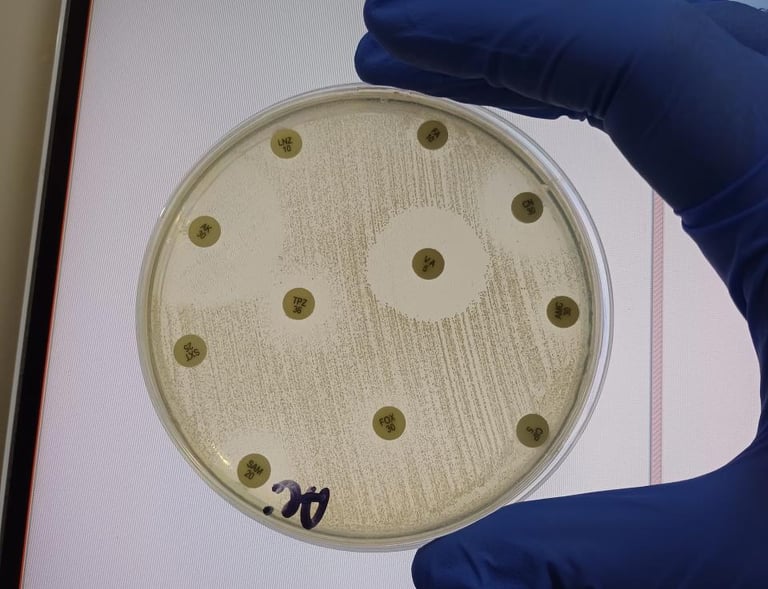
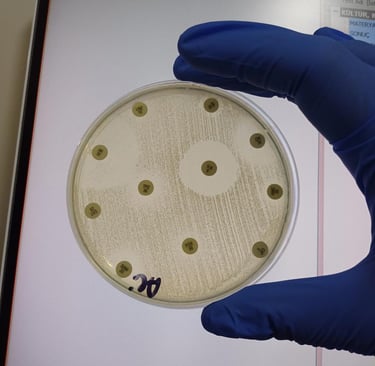

Welcome to Curious Salman
Explore the Blend of Science, Art and Vision
Welcome to Curious Salman!
This is the official website of Emirhan Salman, a molecular biology graduate, science communicator, traditional music enthusiast, gamer, and entrepreneur.
Here, you’ll find:
Science articles focused on biotechnology and molecular genetics.
Saz performances and bağlama tutorials.
Tech and game reviews.
My own product ideas and brand “Curious Charm”.
Let’s explore, create, and connect!
🌍🔬🎶
Get in Touch
Connect with us for insights and collaborations in biotechnology.
Inspiration
Connecting science, creativity, and entrepreneurial spirit.
Explore
Engage
emirhansalman68668@gmail.com
© 2025. All rights reserved.